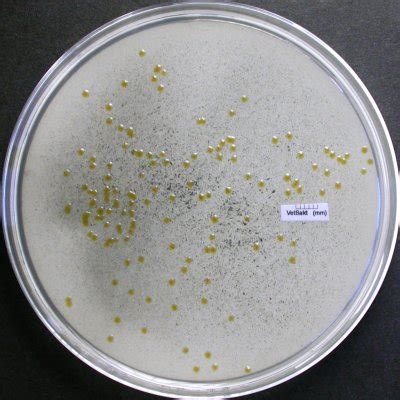
Microfotografía de Flavobacterium psychrophilum.

La acuicultura de salmónidos, especialmente en Chile, enfrenta diversos desafíos sanitarios que impactan la salud de los peces y la productividad. Las enfermedades, tanto infecciosas como no infecciosas, representan un riesgo constante, particularmente durante la delicada fase de agua dulce del ciclo productivo. Los peces en esta etapa son vulnerables a pérdidas significativas, ya sea por bajo desempeño, deformidades o mortalidad directa causada por patógenos.

Enfermedades Bacterianas Relevantes en la Acuicultura de Salmónidos
Las bacterias son uno de los principales riesgos en la salmonicultura, afectando la salud de los peces en diversos grados, desde la disminución del apetito hasta septicemias y mortalidad. El control de estos agentes es crucial, especialmente considerando que Chile es el segundo mayor productor de salmón del mundo.
Flavobacteriosis
La flavobacteriosis, causada principalmente por Flavobacterium psychrophilum, es una de las enfermedades bacterianas más prevalentes y preocupantes en la acuicultura de salmónidos. Esta patología se activa fácilmente bajo condiciones de estrés en los peces y ha demostrado una persistencia considerable a lo largo del tiempo, dificultando el desarrollo de vacunas efectivas.
Los estudios recientes indican que algunas cepas de F. psychrophilum presentan Concentraciones Mínimas Inhibitorias (CIM) muy elevadas y variaciones específicas poco comunes, lo que reduce la efectividad de las terapias antibióticas convencionales. Esto ha llevado a algunas empresas a desarrollar autovacunas como alternativa.
Es importante diferenciarla de Flavobacterium columnare, otro agente del mismo género que causa la flavobacteriosis ulcerativa. Mientras que F. psychrophilum prospera en aguas a 12 °C o menos, F. columnare se presenta cuando la temperatura del agua supera los 16 °C. Ambas bacterias afectan a los peces tanto externa como internamente, provocando lesiones en la piel, aletas y branquias.
Enfermedad Bacteriana del Riñón (BKD)
La Enfermedad Bacteriana del Riñón (BKD), causada por Renibacterium salmoninarum, es un patógeno que, aunque se expresa mayormente en la fase marina, infecta primariamente a los peces en agua dulce, a menudo de forma asintomática. La bacteria puede persistir y transmitirse horizontalmente durante la etapa de engorda.
En Chile, la BKD no se considera una enfermedad de alta significancia, pero su presentación puede generar complicaciones, requiriendo terapia antibiótica y predisponiendo a otras infecciones debido a su cronicidad y el deterioro inmunológico progresivo que provoca. Una característica preocupante de esta bacteria es su resistencia a los procesos de desinfección y la variabilidad en la virulencia de sus cepas.
La transmisión vertical desde reproductores es considerada muy baja e improbable en Chile gracias a los rigurosos y efectivos programas de screening normativos. Sin embargo, la detección del agente causal en poblaciones aparentemente sanas puede ser difícil. Las pruebas de PCR no siempre detectan la positividad debido a posibles cargas bacterianas bajas, lo que ha llevado a explorar métodos alternativos como la medición de anticuerpos para complementar el diagnóstico y anticipar riesgos.

Otras Enfermedades Bacterianas Relevantes
La acuicultura de salmónidos puede verse afectada por una variedad de otras enfermedades bacterianas, entre las que se destacan:
- Septicemia Rickettsial Salmonídea (SRS): Causada por Piscirickettsia salmonis, es altamente infecciosa en la etapa de agua de mar, presentando lesiones multisistémicas en piel y órganos internos. No sobrevive en agua dulce.
- Tenacibaculosis: Una enfermedad emergente de alto riesgo, causada por bacterias del género Tenacibaculum (como T. dicentrarchi, T. finnmarkiensi y T. maritimum). Se caracteriza por lesiones externas notorias en aletas y piel, con úlceras que pueden exponer la musculatura. Afecta también órganos internos como el hígado y el bazo. Se ha observado un aumento en su diagnóstico desde 2018.
- Septicemia Hemorrágica: Causada por Aeromonas salmonicida, se manifiesta con abscesos y úlceras en la piel que exponen el tejido muscular. Su presencia ha disminuido gracias a los protocolos de vacunación.
- Vibriosis: Provocada por Vibrio anguillarum o Vibrio ordalii, bacterias exclusivamente marinas. Causa lesiones cutáneas como úlceras y abscesos, hemorragias en aletas y opacidad, además de lesiones hemorrágicas y anemia en órganos internos.
- Enteritis de la Boca Roja (ERM): Causada por Yersinia ruckeri en agua dulce. Presenta congestión y hemorragias en boca, labios, lengua y opérculos, así como exoftalmia y lesiones cutáneas. Internamente, afecta hígado, vejiga natatoria, páncreas y ciegos pilóricos.

Enfermedades Virales en Acuicultura
Los avances tecnológicos y la experiencia en veterinaria acuática han incrementado la identificación de enfermedades virales. Aunque las opciones de manejo son limitadas, el desarrollo de vacunas es una estrategia en curso para virus de importancia económica.
Novirhabdovirus
- Necrosis Hematopoyética Infecciosa (NHI): Causada por un novirhabdovirus, es una enfermedad de declaración obligatoria. Afecta a diversas especies de salmónidos y truchas, presentándose de forma aguda en alevines con alta mortalidad y pocos signos externos. La enfermedad se manifiesta a temperaturas de 10-12 °C, aunque puede ocurrir a temperaturas más altas. Los signos típicos incluyen letargo, hiperexcitabilidad, oscurecimiento y abdomen distendido. El tejido hematopoyético del riñón y bazo es el más afectado. Existe una vacuna disponible en EE. UU.
- Septicemia Hemorrágica Viral (SHV): También causada por un novirhabdovirus, es una enfermedad altamente regulada. Se presenta en formas aguda, crónica y nerviosa. La forma aguda en alevines puede causar mortalidad del 80-100%, con necrósis del riñón, hígado pálido y hemorragias sistémicas. La temperatura óptima para la infección es de 9-12 °C. No existe una vacuna comercial disponible.
Iridovirus
- Necrosis Eritrocítica Viral (VEN): Descrita en más de 20 especies de peces marinos y anádromos, se caracteriza por la degeneración eritrocítica y anemia. Los peces enfermos presentan palidez en branquias y órganos internos. La lesión característica es un cuerpo de inclusión citoplasmático eosinofílico en los eritrocitos. El agente causal aún no se ha aislado con éxito.
- Necrosis Hematopoyética Epizoótica (EHN): Causada por ranavirus, se caracteriza por lesiones necróticas en el endotelio de los vasos y lesiones viscerales. Los signos conductuales incluyen letargo y natación errática, con mortalidad tras 4-5 días. La lesión más común es la necrosis focal del tejido hematopoyético en el riñón y el hígado. No hay evidencia de transmisión vertical ni portadores detectados en la perca.
- Virus de la Perca Americana: Asociado a ranavirus, se ha aislado de percas americanas, aunque la enfermedad no se comprende completamente ya que el virus suele encontrarse en peces clínicamente sanos. Las lesiones descritas son inespecíficas.
- Megalocitivirus: Un grupo emergente de virus dentro de la familia Iridoviridae, asociado a enfermedades en diversas especies de peces de agua dulce y marinos. Los signos clínicos son inespecíficos, incluyendo letargo, anorexia y oscurecimiento.
Herpesvirus
- Enfermedad del Virus del Siluro de Canal (CCV): Una infección aguda y virulenta por herpesvirus en alevines y juveniles de siluro de canal que puede causar alta mortalidad. Los peces infectados muestran signos de ascitis, exoftalmia y hemorragias en las aletas. Existe evidencia de transmisión vertical.
¿Qué es una ENFERMEDAD INFECCIOSA? Transmisión y tipos
Diagnóstico y Prevención de Enfermedades
El diagnóstico precoz de las enfermedades bacterianas y virales es fundamental y depende de la confirmación del agente etiológico mediante pruebas de laboratorio. La capacitación del personal, la revisión continua de la mortalidad y la recolección de muestras para laboratorios de diagnóstico son esfuerzos esenciales.
Importancia del Diagnóstico Veterinario
Dado que las enfermedades bacterianas se tratan con antibióticos, la intervención de un médico veterinario es indispensable para diagnosticar y prescribir el tratamiento adecuado. El uso indiscriminado de antibióticos es perjudicial para los costos de producción, la salud del pez y conlleva el riesgo de aumentar la resistencia bacteriana, que puede ser transmitida a las personas.
Medidas de Bioseguridad y Prevención
La acuicultura debe enfocarse en la prevención de enfermedades. Actualmente, existen vacunas disponibles para la mayoría de las enfermedades bacterianas relevantes, con la excepción de la tenacibaculosis, cuya vacuna está en fase experimental.
El cultivo de salmón simula el ciclo natural del pez, y cada etapa requiere cuidados específicos para evitar la proliferación bacteriana. El agua, tanto dulce como de mar, es un medio favorable para las bacterias. En pisciculturas de agua dulce con estanques, la desinfección del agua mediante filtros ultravioleta u ozono, junto con medidas de bioseguridad, son cruciales. En centros de mar en ambientes abiertos, el control ambiental es más difícil, por lo que las medidas de bioseguridad, como la desinfección de equipos, la limitación del tránsito de personas y embarcaciones, son fundamentales.
Las instalaciones de acuicultura, especialmente aquellas diseñadas para altas densidades de cultivo en la fase de agua dulce, deben implementar sistemas de tratamiento de agua y medidas de bioseguridad para mitigar riesgos.
